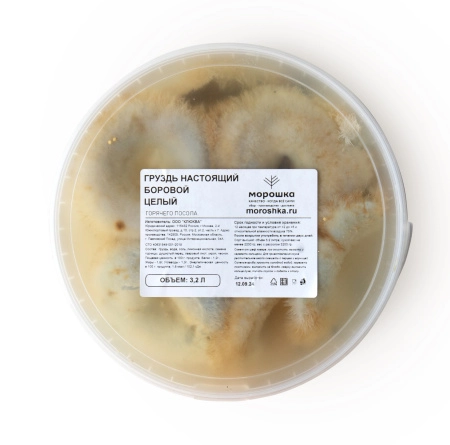
Груздь настоящий БОРОВОЙ соленый, целый, горячий посол, 3,2 л

Артикул:
1903212
Груздь настоящий БОРОВОЙ, целый.
Хорошее качество.
Собственное производство. Горячий посол.
Чистый вес грибов 2,2 кг
Объем - 3,2 л
Хорошее качество.
Собственное производство. Горячий посол.
Чистый вес грибов 2,2 кг
Объем - 3,2 л
Характеристики
Перед употреблением рекомендуем промыть холодной кипяченой водой для регулирования солёности. Продукт готов к употреблению. Не требует дополнительной термической обработки.
белки - 1,4 г, жиры - 0,6 г, углеводы - 1,5 г; энергетическая ценность: 17,3 ккал
Груздь настоящий, вода, соль, лимонная кислота, семена горчицы, душистый перец, лавровый лист, укроп, чеснок. Сорт высший: объём 3,2 литра; сухой вес не менее 2200 г; вес с рассолом 3200 г
Отзывы
Оставить отзыв
Похожие товары